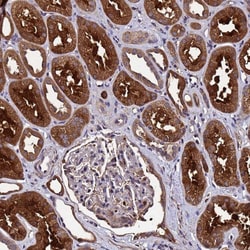
Invitrogen&trade;&nbsp;GSTCD Polyclonal Antibody

missing translation for 'onlineSavingsMsg'
Learn More
Learn More
Invitrogen™ GSTCD Polyclonal Antibody
Rabbit Polyclonal Antibody
Supplier: Invitrogen™ PA561167
Description
Immunogen sequence: TRASFVTCPC CYGFIQNTSK FNFPKSEQFK KTLSYKEHMI LCRFADQTAV QLPPQRRLIG KQCMCLVDLD RARAAEECGY SVQVI Highest antigen sequence identity to the following orthologs: Mouse - 91%, Rat - 92%.
GSTCD (glutathione S-transferase, C-terminal domain containing) is a 633 amino acid protein belonging to the GSTCD family and contains one GST C-terminal domain. The gene encoding GSTCD maps to human chromosome 4, which represents approximately 6% of the human genome and contains nearly 900 genes. Notably, the Huntingtin gene, which is found to encode an expanded glutamine tract in cases of Huntington's disease, is on chromosome 4. FGFR-3 is also encoded on chromosome 4 and has been associated with thanatophoric dwarfism, achondroplasia, Muenke syndrome and bladder cancer.Specifications
| GSTCD | |
| Polyclonal | |
| Unconjugated | |
| Gstcd | |
| 4933434L15Rik; glutathione S-transferase C-terminal domain containing; glutathione S-transferase C-terminal domain-containing protein; glutathione S-transferase, C-terminal domain containing; GSTCD; RGD1311822 | |
| Rabbit | |
| Antigen Affinity Chromatography | |
| RUO | |
| 79807 | |
| Store at 4°C short term. For long term storage, store at -20°C, avoiding freeze/thaw cycles. | |
| Liquid |
| Immunohistochemistry (Paraffin), Immunocytochemistry | |
| 0.05 mg/mL | |
| PBS with 40% glycerol and 0.02% sodium azide; pH 7.2 | |
| Q8NEC7 | |
| Gstcd | |
| Recombinant protein corresponding to Human GSTCD. Recombinant protein control fragment (Product #RP-96665). | |
| 100 μL | |
| Primary | |
| Human | |
| Antibody | |
| IgG |